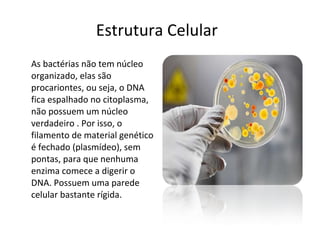
Estrutura Celular As bactérias não tem núcleo organizado, elas são procariontes, ou seja, o DNA fica espalhado no citoplasma, não possuem um núcleo verdadeiro . Por isso, o filamento de material genético é fechado (plasmídeo), sem pontas, para que nenhuma enzima comece a digerir o DNA. Possuem uma parede celular bastante rígida.

1) O documento discute a descoberta e características de vírus e bactérias, incluindo seu papel na saúde e doença humana. 2) Vírus são menores que bactérias e dependem de células vivas para se reproduzirem, enquanto bactérias podem se reproduzir independentemente. 3) Embora ambos possam causar doenças, bactérias também desempenham papéis benéficos como decomposição de matéria orgânica.